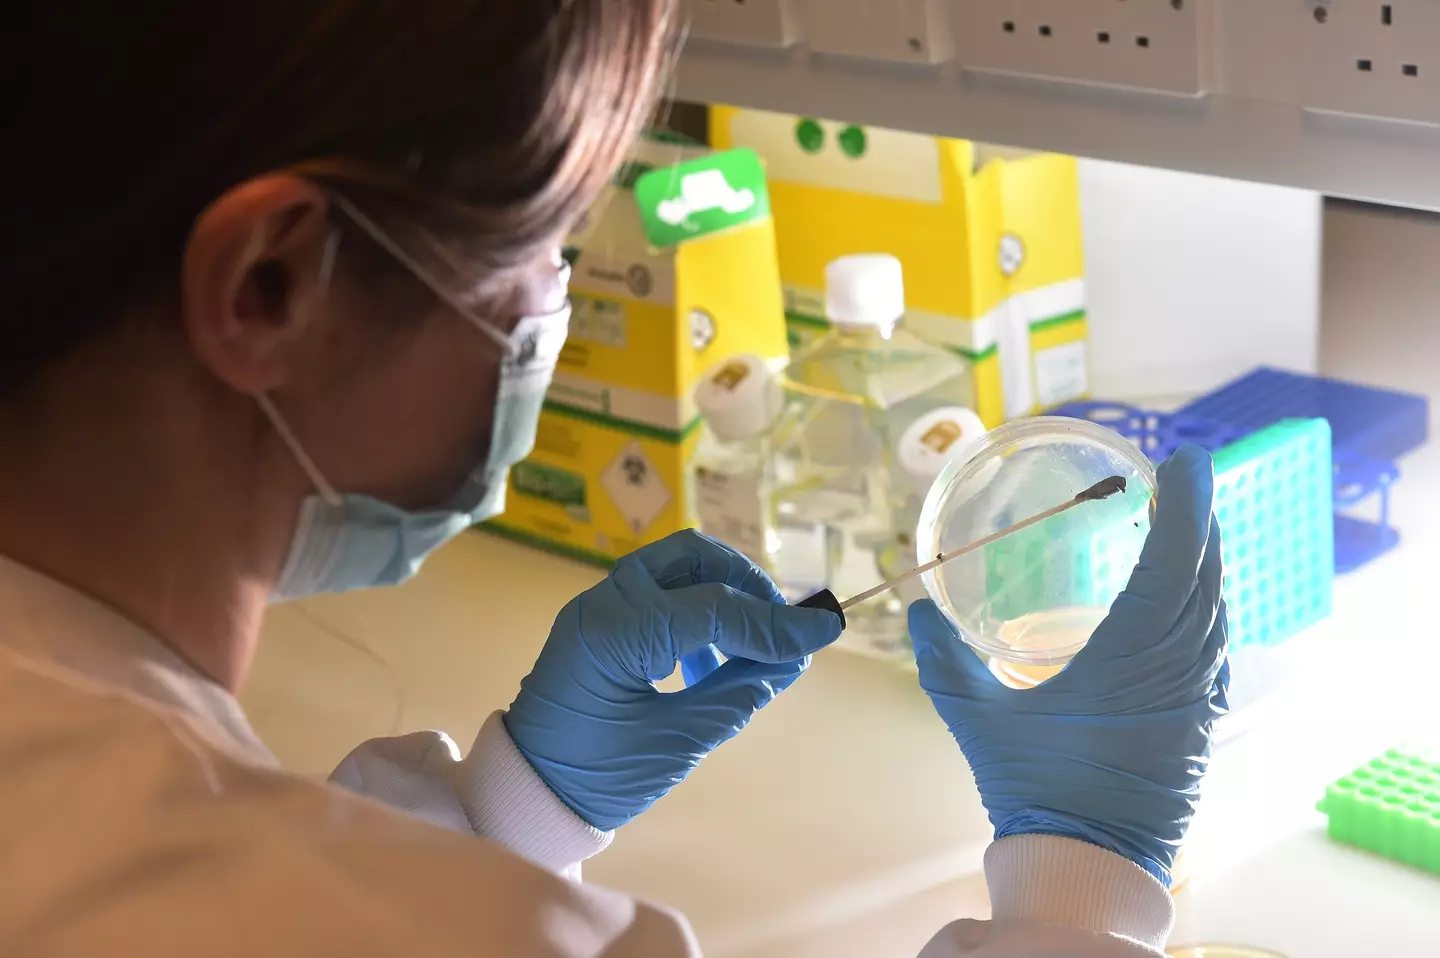
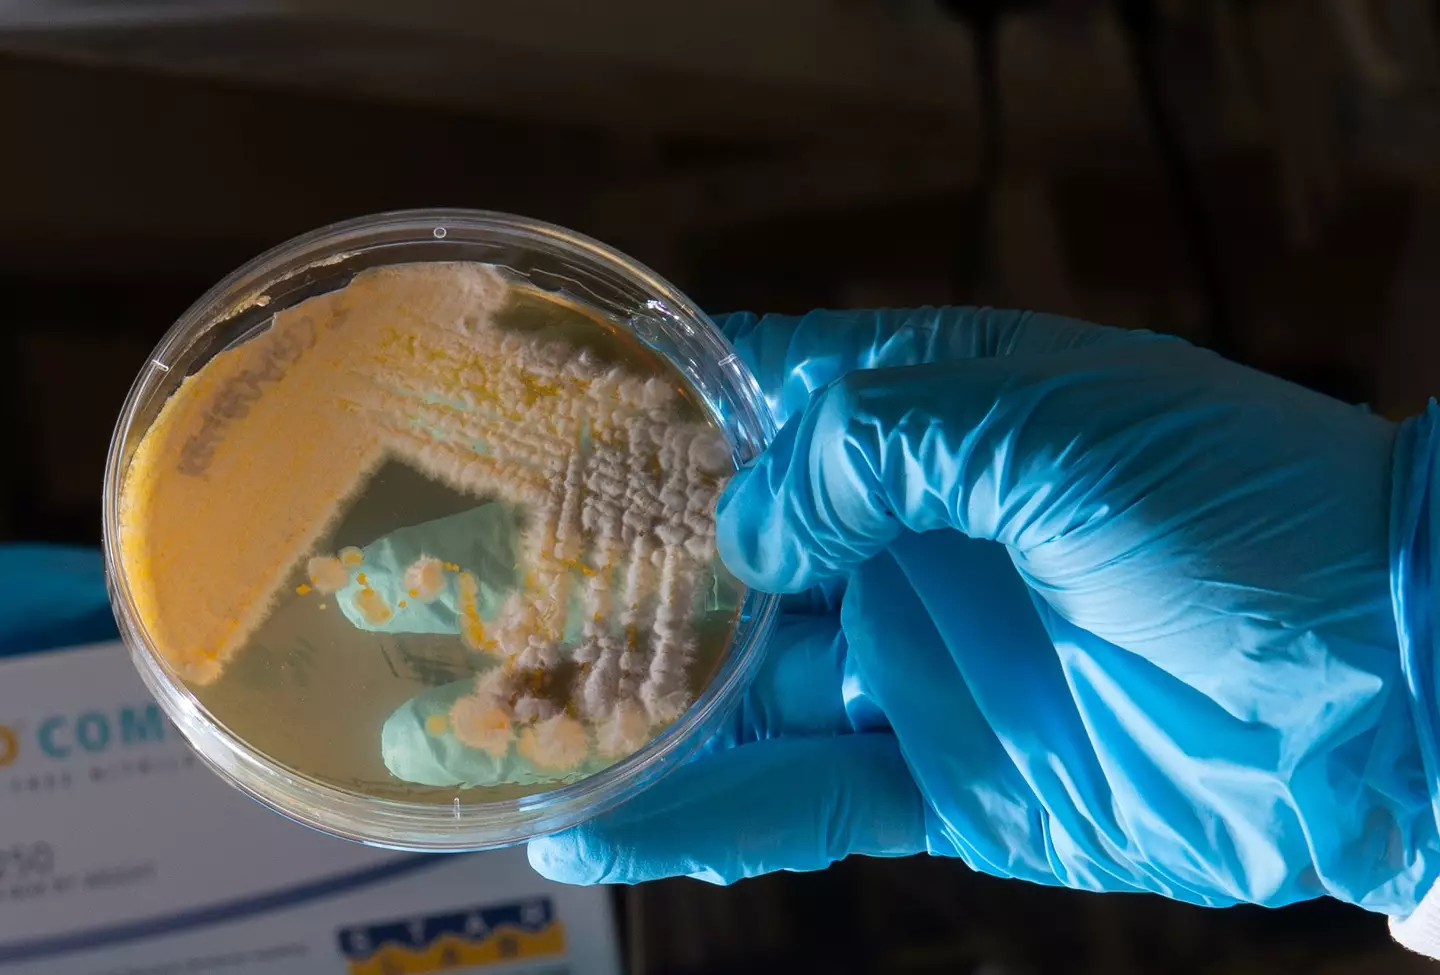

Brits are being warned to wash their hands more regularly this Christmas, after a study conducted on self-service checkouts found all kinds of bugs and bacteria.
The investigation saw scientists analyse swabs from a number of different objects, and the results are pretty shocking.
E.coli - which can cause vomiting - was found on nearly all of the objects tested, meanwhile faeces and microbes that can cause urinary tract infections (UTIs) were present on self-checkouts.
Advert
And that's not all. A bug commonly found in the vagina, mouth, throat and gut called Candida albicans, which can cause yeast infections, was also discovered on an escalator handrail.
If you hot desk at work, you might want to start cleaning down your workstation too, after intestinal microbes that can cause a range of infections, including UTIs, were found on computer keyboards.

Dr Adam Roberts, chief researcher with the Infection Innovation Consortium (iiCON), who produced the research, said: “The self-checkout samples had one of the highest bacterial loads, as we found five different types of potential disease-causing bacteria surviving on them.
Advert
“This included Enterococcus which is found in human faeces and, while this is usually harmless, it can of course lead to disease, particularly in those who may have weakened immune systems.
“We found multiple examples of E. coli and a bacteria called Klebsiella on computer keyboards.
“While both exist naturally in faeces and intestines, given the right environment, they are able to cause quite severe diseases in humans, so it’s vital that we wash our hands before and after eating when working at the computer.”
Dr Roberts also reminded Brits to wash their hands after they had been to the bathroom, too.
Advert
“It’s vital to try to minimise their effects in terms of infection prevention and control, so when we touch our mouths or go to the toilet and don’t wash our hands, we’ve likely got bacteria from these places on our hands which can then transfer to other things – and subsequently to other people," he added. “If those individuals are more susceptible to infection than you are, there may be a problem.”
Meanwhile, Merseyside-based public health partnership, Champs Public Health Collaborative, is also urging Brits to be more vigilant this festive season as part of a wider campaign, Simple Things, which was launched after researchers found two-thirds of people are worried about the spread of infectious diseases this winter.
The campaign highlights four key measures - hand washing, sanitising surfaces, keeping a distance when unwell and covering sneezes or coughs.
Advert
Matt Ashton, Director of Public Health for Liverpool, said: “These bacteria are completely invisible to the naked eye – surfaces may look clean but can be covered in bacteria.
“But there are simple things we can do to prevent the spread of them and stop the transfer completing its cycle.
“This is particularly important if you are visiting vulnerable relatives in hospitals and care homes, for example."
Brb, we're off to wash our hands.
Topics: Health